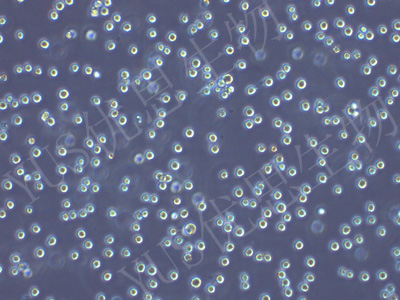

产品中心
产品中心
-

RBE 人肝胆管癌细胞(STR鉴定)
货号:YLH439规格: 1*10^6 -

SNU-398 人肝癌细胞(STR鉴定)
货号:YLH440规格: 1*10^6 -

BJ 人皮肤成纤维细胞(STR鉴定)
货号:YLH442规格: 1*10^6 -

NCM460 人正常结肠上皮细胞(STR鉴定)
货号:YLH443规格: 1*10^6 -

SW780 人膀胱移行细胞癌(STR鉴定)
货号:YLH445规格: 1*10^6 -

HEC-1-B 人子宫内膜腺癌细胞(STR鉴定)
货号:YLH446规格: 1*10^6 -

JHH-7 人肝癌细胞(STR鉴定)
货号:YLH448规格: 1*10^6 -

HLE-B3 人晶状体上皮细胞(STR鉴定)
货号:YLH449规格: 1*10^6 -

HT29 MTX E12 甲氨蝶呤诱导HT29细胞分化为成熟杯状细胞(STR鉴定)
货号:YLH450规格: 1*10^6 -

MH7A 人关节炎成纤维细胞(STR鉴定)
货号:YLH452规格: 1*10^6 -

OCI-LY10 人弥漫大B淋巴瘤细胞(STR鉴定)
货号:YLH453规格: 1*10^6 -
skm-1 人急性髓系白血病细胞(STR鉴定)
货号:YLH454规格: 1*10^6
在线咨询
Online consultation

关注微信公众号


